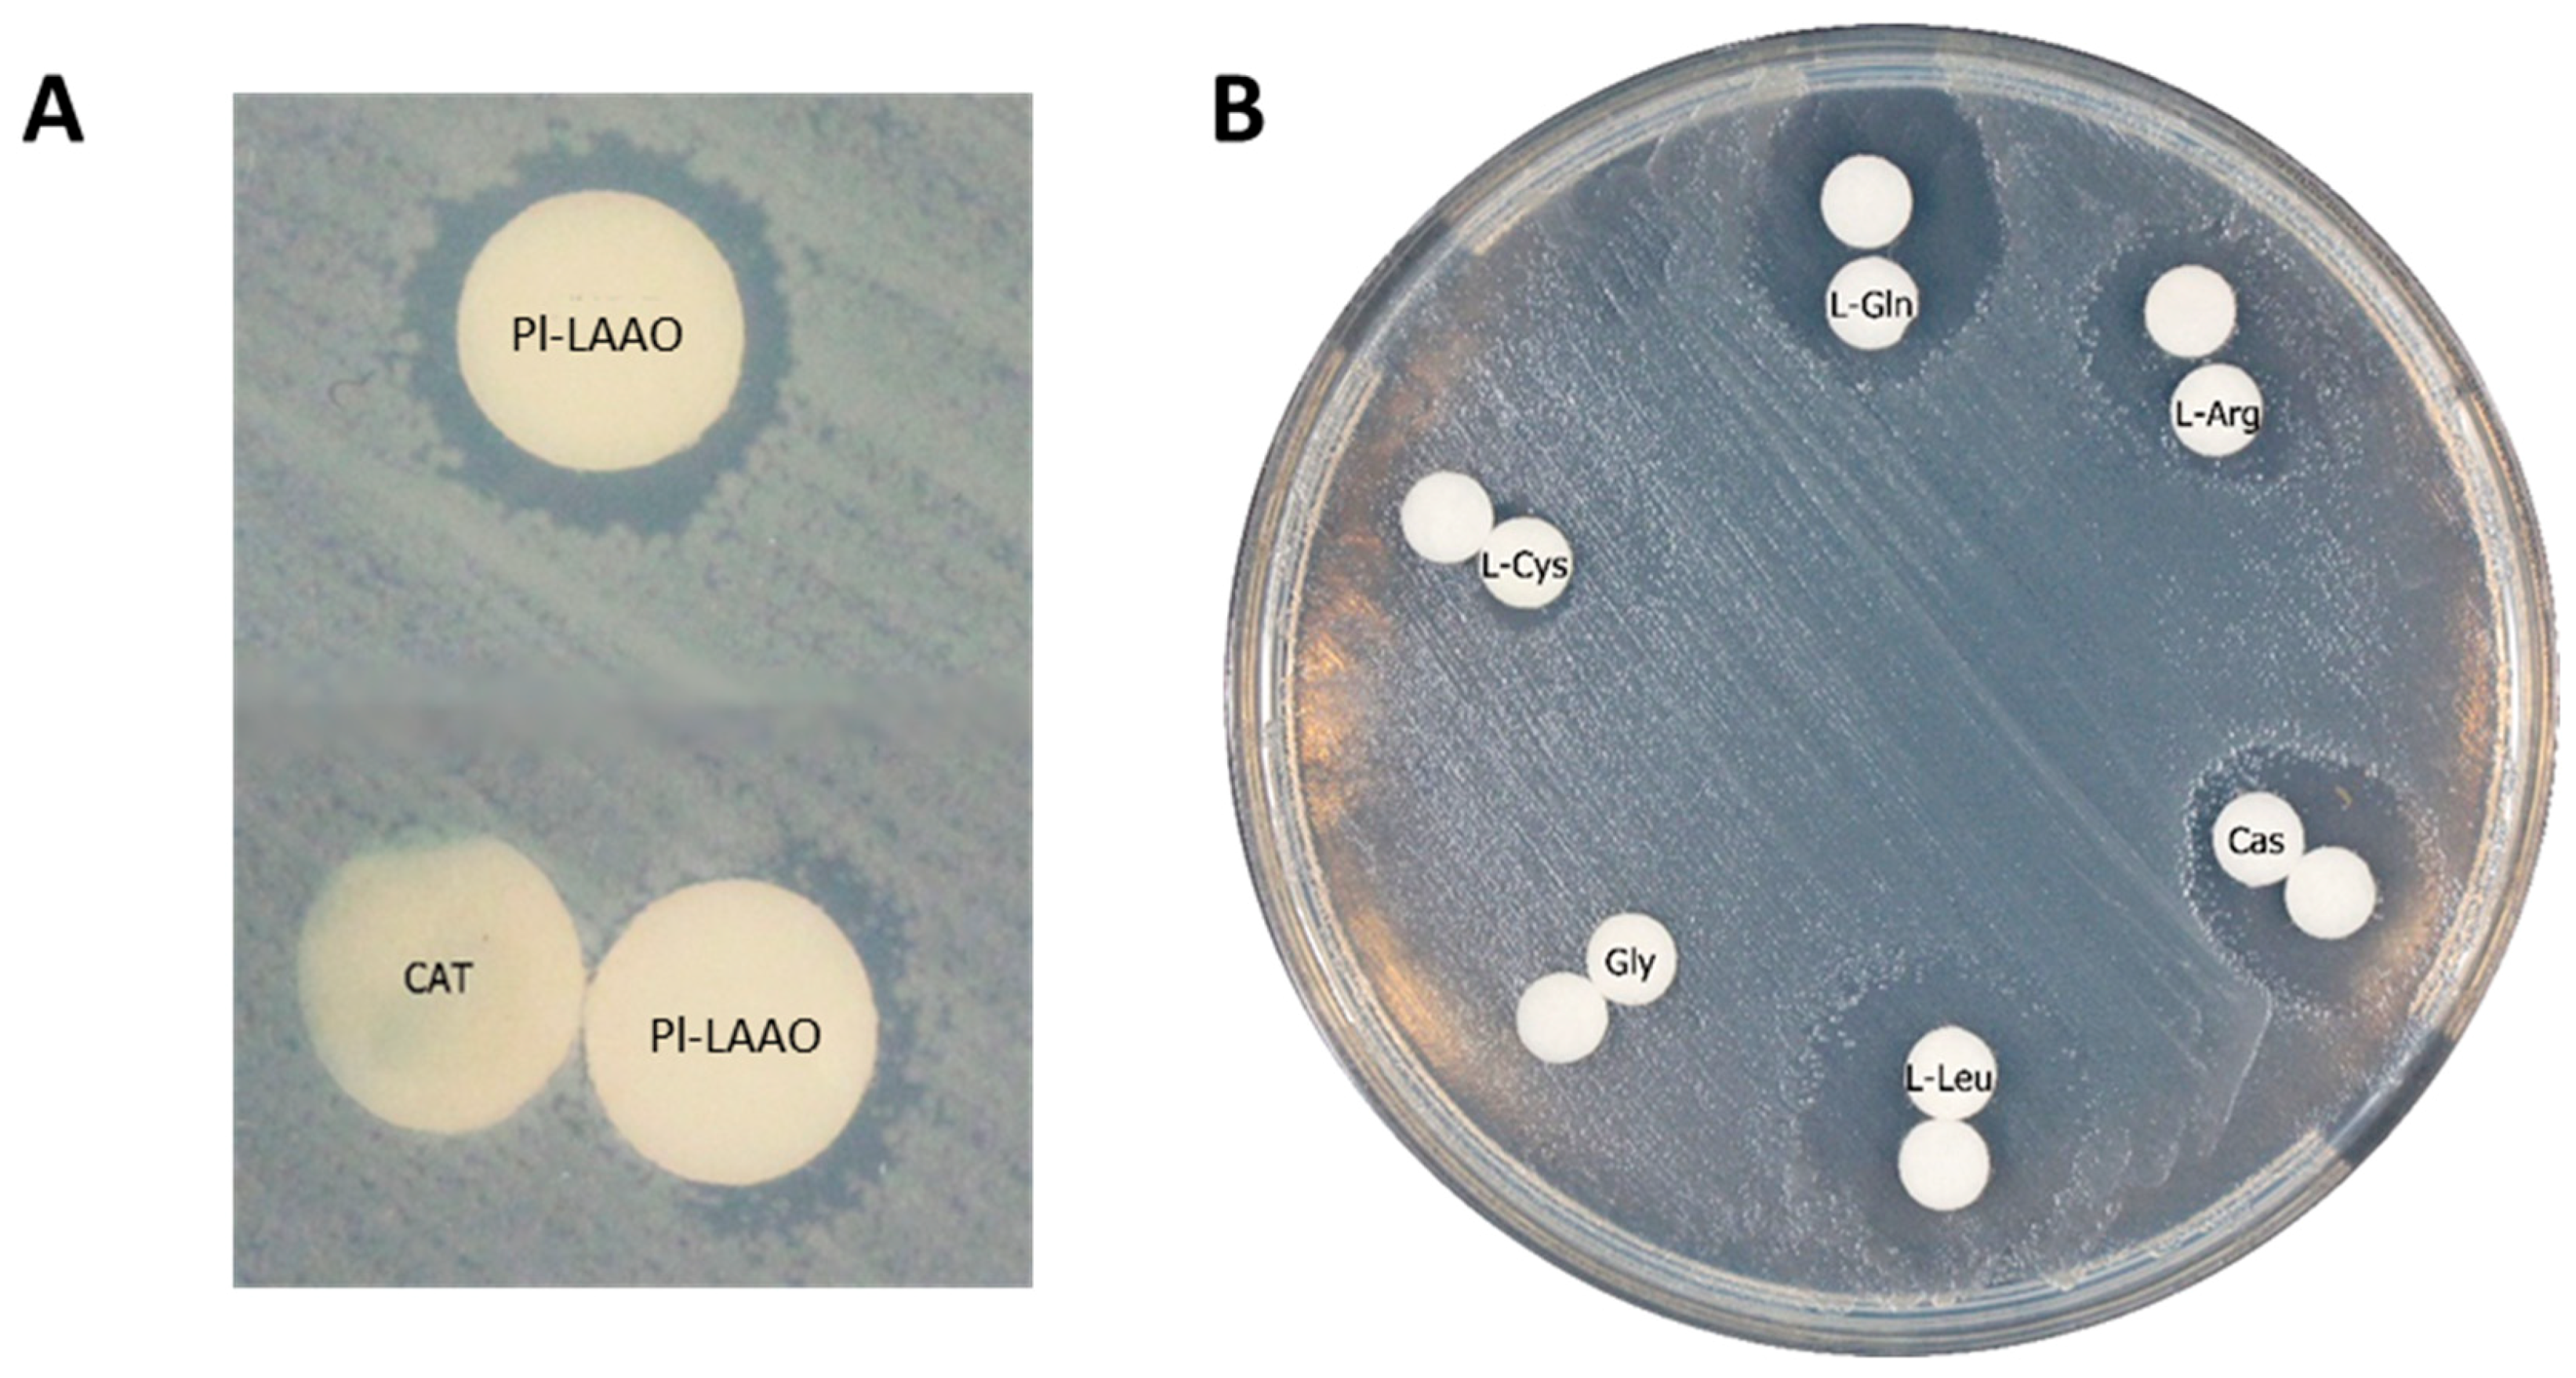
Marinedrugs 16 00499 g006

The Pseudoalteromonas luteoviolacea L-amino Acid Oxidase with Antimicrobial Activity Is a Flavoenzyme
Abstract
:1. Introduction
2. Results
2.1. Identification of the Gene Encoding the LAAO Activity in CPMOR-2 Strain
2.2. Sequence Analysis of Pl-LAAO
2.3. Recombinant Expression and Partial Biochemical Characterization of Pl-LAAO
2.4. Detection, Distribution, and Phylogenetic Analysis of Proteins Similar to Pl-LAAO
3. Discussion
4. Materials and Methods
4.1. Strains, Culture Media, Plasmids, and Primers
4.2. DNA Manipulations
4.3. Expression and Purification of Recombinant Protein
4.4. SDS-PAGE
4.5. Activity Assays
4.6. UV-VIS Spectrum
4.7. Mass Spectrometry Analysis
4.8. Detection, Alignment, and Phylogenetic Analysis of Pl-LAAO Similar Proteins
Supplementary Materials
Author Contributions
Funding
Acknowledgments
Conflicts of Interest
References
- Desriac, F.; Rodrigues, S.; Doghri, I.; Sablé, S.; Isabelle, L.; Fleury, Y.; Bazire, A.; Dufour, A. Biostructures, biomaterials, and biomolecules for other applications. In Blue Biotechnology: Production and Use of Marine Molecules, 1st ed.; Wiley-VCH Verlag GmbH & Co. KGaA: Weinheim, Germany, 2018; pp. 791–809. [Google Scholar]
- May-Zin, W.W.; Buttachon, S.; Dethoup, T.; Fernandes, C.; Cravo, S.; Pinto, M.M.; Gales, L.; Pereira, J.A.; Silva, A.M.; Sekeroglu, N.; et al. New cyclotetrapeptides and a new diketopiperzine derivative from the marine sponge-associated fungus Neosartorya glabra KUFA 0702. Mar. Drugs 2016, 14. [Google Scholar] [CrossRef] [PubMed]
- Bowman, J.P. Bioactive compound synthetic capacity and ecological significance of marine bacterial genus Pseudoalteromonas. Mar. Drugs 2007, 5, 220–241. [Google Scholar] [CrossRef] [PubMed]
- Campillo-Brocal, J.C.; Chacon-Verdu, M.D.; Lucas-Elio, P.; Sanchez-Amat, A. Distribution in microbial genomes of genes similar to lodA and goxA which encode a novel family of quinoproteins with amino acid oxidase activity. BMC Genom. 2015, 16, 231. [Google Scholar] [CrossRef] [PubMed]
- Campillo-Brocal, J.C.; Lucas-Elio, P.; Sanchez-Amat, A. Distribution in different organisms of amino acid oxidases with FAD or a quinone as cofactor and their role as antimicrobial proteins in marine bacteria. Mar. Drugs 2015, 13, 7403–7418. [Google Scholar] [CrossRef] [PubMed]
- Gomez, D.; Lucas-Elio, P.; Sanchez-Amat, A.; Solano, F. A novel type of lysine oxidase: L-lysine-epsilon-oxidase. Biochim. Biophys. Acta 2006, 1764, 1577–1585. [Google Scholar] [CrossRef] [PubMed]
- Izidoro, L.F.; Sobrinho, J.C.; Mendes, M.M.; Costa, T.R.; Grabner, A.N.; Rodrigues, V.M.; da Silva, S.L.; Zanchi, F.B.; Zuliani, J.P.; Fernandes, C.F.; et al. Snake venom L-amino acid oxidases: trends in pharmacology and biochemistry. Biomed. Res. Int. 2014, 2014, 196754. [Google Scholar] [CrossRef] [PubMed]
- Yu, Z.; Qiao, H. Advances in non-snake venom L-amino acid oxidase. Appl. Biochem. Biotechnol. 2012, 167, 1–13. [Google Scholar] [CrossRef] [PubMed]
- Yang, C.A.; Cheng, C.H.; Liu, S.Y.; Lo, C.T.; Lee, J.W.; Peng, K.C. Identification of antibacterial mechanism of L-amino acid oxidase derived from Trichoderma harzianum ETS 323. FEBS J. 2011, 278, 3381–3394. [Google Scholar] [CrossRef] [PubMed]
- Kitani, Y.; Toyooka, K.; Endo, M.; Ishizaki, S.; Nagashima, Y. Intra-tissue localization of an antibacterial L-amino acid oxidase in the rockfish Sebastes schlegeli. Dev. Comp. Immunol. 2013, 39, 456–459. [Google Scholar] [CrossRef] [PubMed]
- Hossain, G.S.; Li, J.; Shin, H.D.; Du, G.; Liu, L.; Chen, J. L-Amino acid oxidases from microbial sources: types, properties, functions, and applications. Appl. Microbiol. Biotechnol. 2014, 98, 1507–1515. [Google Scholar] [CrossRef]
- Mai-Prochnow, A.; Lucas-Elio, P.; Egan, S.; Thomas, T.; Webb, J.S.; Sanchez-Amat, A.; Kjelleberg, S. Hydrogen peroxide linked to lysine oxidase activity facilitates biofilm differentiation and dispersal in several gram-negative bacteria. J. Bacteriol. 2008, 190, 5493–5501. [Google Scholar] [CrossRef] [PubMed]
- Yu, M.; Wang, J.; Tang, K.; Shi, X.; Wang, S.; Zhu, W.M.; Zhang, X.H. Purification and characterization of antibacterial compounds of Pseudoalteromonas flavipulchra JG1. Microbiology 2012, 158, 835–842. [Google Scholar] [CrossRef] [PubMed]
- Chen, W.M.; Lin, C.Y.; Chen, C.A.; Wang, J.T.; Sheu, S.Y. Involvement of an l-amino acid oxidase in the activity of the marine bacterium Pseudoalteromonas flavipulchra against methicillin-resistant Staphylococcus aureus. Enzyme Microb. Technol. 2010, 47, 52–58. [Google Scholar] [CrossRef]
- McCarthy, S.A.; Johnson, R.M.; Kakimoto, D. Characterization of an antibiotic produced by Alteromonas luteoviolacea Gauthier 1982, 85 isolated from Kinko Bay, Japan. J. Appl. Bacteriol. 1994, 77, 426–432. [Google Scholar] [CrossRef] [PubMed]
- Gomez, D.; Espinosa, E.; Bertazzo, M.; Lucas-Elio, P.; Solano, F.; Sanchez-Amat, A. The macromolecule with antimicrobial activity synthesized by Pseudoalteromonas luteoviolacea strains is an L-amino acid oxidase. Appl. Microbiol. Biotechnol. 2008, 79, 925–930. [Google Scholar] [CrossRef] [PubMed]
- Chen, W.M.; Sheu, F.S.; Sheu, S.Y. Novel L-amino acid oxidase with algicidal activity against toxic cyanobacterium Microcystis aeruginosa synthesized by a bacterium Aquimarina sp. Enzyme Microb. Technol. 2011, 49, 372–379. [Google Scholar] [CrossRef] [PubMed]
- Andreo-Vidal, A.; Mamounis, K.J.; Sehanobish, E.; Avalos, D.; Campillo-Brocal, J.C.; Sanchez-Amat, A.; Yukl, E.T.; Davidson, V.L. Structure and enzymatic properties of an unusual cysteine tryptophylquinone-dependent glycine oxidase from Pseudoalteromonas luteoviolacea. Biochemistry 2018. [Google Scholar] [CrossRef] [PubMed]
- Campillo-Brocal, J.C.; Lucas-Elio, P.; Sanchez-Amat, A. Identification in Marinomonas mediterranea of a novel quinoprotein with glycine oxidase activity. Microbiologyopen 2013, 2, 684–694. [Google Scholar] [CrossRef] [PubMed]
- Dym, O.; Eisenberg, D. Sequence-structure analysis of FAD-containing proteins. Protein Sci. 2001, 10, 1712–1728. [Google Scholar] [CrossRef] [PubMed] [Green Version]
- Bottoms, C.A.; Smith, P.E.; Tanner, J.J. A structurally conserved water molecule in Rossmann dinucleotide-binding domains. Protein Sci. 2002, 11, 2125–2137. [Google Scholar] [CrossRef] [PubMed]
- Vallon, O. New sequence motifs in flavoproteins: evidence for common ancestry and tools to predict structure. Proteins 2000, 38, 95–114. [Google Scholar] [CrossRef]
- Yu, Z.; Zhou, N.; Qiao, H.; Qiu, J. Identification, cloning, and expression of L-amino acid oxidase from marine Pseudoalteromonas sp. B3. Sci. World J. 2014, 2014, 979858. [Google Scholar] [CrossRef]
- Ehara, T.; Kitajima, S.; Kanzawa, N.; Tamiya, T.; Tsuchiya, T. Antimicrobial action of achacin is mediated by L-amino acid oxidase activity. FEBS Lett. 2002, 531, 509–512. [Google Scholar] [CrossRef]
- Kishishita, S.; Okajima, T.; Kim, M.; Yamaguchi, H.; Hirota, S.; Suzuki, S.; Kuroda, S.; Tanizawa, K.; Mure, M. Role of copper ion in bacterial copper amine oxidase: spectroscopic and crystallographic studies of metal-substituted enzymes. J. Am. Chem. Soc. 2003, 125, 1041–1055. [Google Scholar] [CrossRef] [PubMed]
- Hahn, K.; Hertle, Y.; Bloess, S.; Kottke, T.; Hellweg, T.; Fischer von Mollard, G. Activation of recombinantly expressed L-amino acid oxidase from Rhizoctonia solani by Sodium Dodecyl Sulfate. Molecules 2017, 22. [Google Scholar] [CrossRef] [PubMed]
- Kamio, M.; Ko, K.C.; Zheng, S.; Wang, B.; Collins, S.L.; Gadda, G.; Tai, P.C.; Derby, C.D. The chemistry of escapin: Identification and quantification of the components in the complex mixture generated by an L-amino acid oxidase in the defensive secretion of the sea snail Aplysia californica. Chemistry 2009, 15, 1597–1603. [Google Scholar] [CrossRef]
- Tamura, K.; Stecher, G.; Peterson, D.; Filipski, A.; Kumar, S. MEGA6: Molecular evolutionary genetics analysis version 6.0. Mol. Biol. Evol. 2013, 30, 2725–2759. [Google Scholar] [CrossRef]
- Gauthier, M.J. Modification of bacterial respiration by a macromolecular polyanionic antibiotic produced by a marine Alteromonas. Antimicrob. Agents Chemother. 1976, 9, 361–366. [Google Scholar] [CrossRef]
- Lucas-Elio, P.; Gomez, D.; Solano, F.; Sanchez-Amat, A. The antimicrobial activity of marinocine, synthesized by Marinomonas mediterranea, is due to hydrogen peroxide generated by its lysine oxidase activity. J. Bacteriol. 2006, 188, 2493–2501. [Google Scholar] [CrossRef]
- Chen, W.M.; Lin, C.Y.; Sheu, S.Y. Investigating antimicrobial activity in Rheinheimera sp. due to hydrogen peroxide generated by L-lysine oxidase activity. Enzyme Microb. Technol. 2010, 46, 487–493. [Google Scholar] [CrossRef]
- Davis, M.A.; Askin, M.C.; Hynes, M.J. Amino acid catabolism by an areA-regulated gene encoding an L-amino acid oxidase with broad substrate specificity in Aspergillus nidulans. Appl. Environ. Microbiol. 2005, 71, 3551–3555. [Google Scholar] [CrossRef] [PubMed]
- Nuutinen, J.T.; Marttinen, E.; Soliymani, R.; Hildén, K.; Timonen, S. L-Amino acid oxidase of the fungus Hebeloma cylindrosporum displays substrate preference towards glutamate. Microbiology 2012, 158, 272–283. [Google Scholar] [CrossRef] [PubMed]
- Yang, H.; Johnson, P.M.; Ko, K.C.; Kamio, M.; Germann, M.W.; Derby, C.D.; Tai, P.C. Cloning, characterization and expression of escapin, a broadly antimicrobial FAD-containing L-amino acid oxidase from ink of the sea hare Aplysia californica. J. Exp. Biol. 2005, 208, 3609–3622. [Google Scholar] [CrossRef] [PubMed]
- Solano, F.; Garcia, E.; Perez, D.; Sanchez-Amat, A. Isolation and characterization of strain MMB-1 (CECT 4803), a novel melanogenic marine bacterium. Appl. Environ. Microbiol. 1997, 63, 3499–3506. [Google Scholar] [PubMed]
- Hernandez-Romero, D.; Lucas-Elio, P.; Lopez-Serrano, D.; Solano, F.; Sanchez-Amat, A. Marinomonas mediterranea is a lysogenic bacterium that synthesizes R-bodies. Microbiology 2003, 149, 2679–2686. [Google Scholar] [CrossRef] [PubMed]
- Molina-Quintero, L.R.; Lucas-Elio, P.; Sanchez-Amat, A. Regulation of the Marinomonas mediterranea antimicrobial protein lysine oxidase by L-lysine and the sensor histidine kinase PpoS. Appl. Environ. Microbiol. 2010, 76, 6141–6149. [Google Scholar] [CrossRef] [PubMed]
- Sambrook, J.F.; Russell, D.W. Molecular Cloning: A Laboratory Manual; Cold Spring Harbor Laboratory Press: Cold Spring Harbor, NY, USA, 2001. [Google Scholar]
- Loewen, P.C.; Switala, J.; Triggs-Raine, B.L. Catalases HPI and HPII in Escherichia coli are induced independently. Arch. Biochem. Biophys. 1985, 243, 144–149. [Google Scholar] [CrossRef]
- Dower, W.J.; Miller, J.F.; Ragsdale, C.W. High efficiency transformation of E. coli by high voltage electroporation. Nucleic Acids Res. 1988, 16, 6127–6145. [Google Scholar] [CrossRef]
- Laemmli, U.K. Cleavage of structural proteins during the assembly of the head of bacteriophage T4. Nature 1970, 227, 680–685. [Google Scholar] [CrossRef]
- Bhunia, A.K.; Johson, M.C.; Ray, B. Direct detection of an antimicrobial peptide of Pediococcus acidilactici in sodium dodecyl sulfate-polyacrylamide gel electrophoresis. J. Ind. Microbiol. 1987, 2, 319–322. [Google Scholar] [CrossRef]
- Lucas-Elio, P.; Hernandez, P.; Sanchez-Amat, A.; Solano, F. Purification and partial characterization of marinocine, a new broad-spectrum antibacterial protein produced by Marinomonas mediterranea. Biochim. Biophys. Acta 2005, 1721, 193–203. [Google Scholar] [CrossRef] [PubMed]
- Chen, I.A.; Markowitz, V.M.; Chu, K.; Palaniappan, K.; Szeto, E.; Pillay, M.; Ratner, A.; Huang, J.; Andersen, E.; Huntemann, M.; et al. IMG/M: Integrated genome and metagenome comparative data analysis system. Nucleic Acids Res. 2017, 45, D507–D516. [Google Scholar] [CrossRef] [PubMed]
- Edgar, R.C. Muscle: Multiple sequence alignment with high accuracy and high throughput. Nucleic Acids Res. 2004, 32, 1792–1797. [Google Scholar] [CrossRef] [PubMed]

| Taxon | Phylogenetic Group 1 | Phylogenetic Group 2 | Phylogenetic Group 3 | Ungrouped |
|---|---|---|---|---|
| Proteobacteria (29907) | 28 | 0 | 1 | 1 |
| * Alphaproteobacteria (4218) | 0 | 0 | 1 | 0 |
| * Gammaproteobacteria (19977) | 28 | 0 | 0 | 0 |
| * Betaproteobacteria (3182) | 0 | 0 | 0 | 1 |
| Bacteroidetes (2483) | 0 | 8 | 5 | 5 |
| * Saprospiria (15) | 0 | 0 | 2 | 0 |
| * Flavobacteriia (1009) | 0 | 0 | 3 | 0 |
| * Cytophagia (229) | 0 | 8 | 0 | 4 |
| * Unclassified (216) | 0 | 0 | 0 | 1 |
| Nitrospinae (54) | 0 | 0 | 1 | 0 |
| * Nitrospinia (21) | 0 | 0 | 1 | 0 |
| TOTAL | 28 | 8 | 7 | 6 |
| Strains | Relevant Genotype and Description, or Sequence | Reference or Source |
|---|---|---|
| Pseudoalteromonas luteoviolacea CPMOR-2 | Wild-type | [16] |
| Escherichia coli CD03 | BL21(DE3) katE12::Tn10 katG::Tn5, [Cat+/−] | [25] |
| Escherichia coli UM202 | MP180 katG::Tn10, [Cat+/−] | [39] |
| Plasmids | ||
| pET15b | pET15b | Novagen |
| pETpl-laao.15 | pET15b, Pl-laao | This study |
| Primers 1 | ||
| AminoORCPMOR2Nde (D) | 5′-AAGGAATACATATGACACATTATACTTTTGG-3′ | |
| AminoORCPMOR2Bam (R) | 5′-CTTCTAACGGATCCTTAAAGTAATCTG-3′ |
© 2018 by the authors. Licensee MDPI, Basel, Switzerland. This article is an open access article distributed under the terms and conditions of the Creative Commons Attribution (CC BY) license (http://creativecommons.org/licenses/by/4.0/).
Share and Cite
Andreo-Vidal, A.; Sanchez-Amat, A.; Campillo-Brocal, J.C. The Pseudoalteromonas luteoviolacea L-amino Acid Oxidase with Antimicrobial Activity Is a Flavoenzyme. Mar. Drugs 2018, 16, 499. https://doi.org/10.3390/md16120499
Andreo-Vidal A, Sanchez-Amat A, Campillo-Brocal JC. The Pseudoalteromonas luteoviolacea L-amino Acid Oxidase with Antimicrobial Activity Is a Flavoenzyme. Marine Drugs. 2018; 16(12):499. https://doi.org/10.3390/md16120499
Chicago/Turabian StyleAndreo-Vidal, Andrés, Antonio Sanchez-Amat, and Jonatan C. Campillo-Brocal. 2018. "The Pseudoalteromonas luteoviolacea L-amino Acid Oxidase with Antimicrobial Activity Is a Flavoenzyme" Marine Drugs 16, no. 12: 499. https://doi.org/10.3390/md16120499
APA StyleAndreo-Vidal, A., Sanchez-Amat, A., & Campillo-Brocal, J. C. (2018). The Pseudoalteromonas luteoviolacea L-amino Acid Oxidase with Antimicrobial Activity Is a Flavoenzyme. Marine Drugs, 16(12), 499. https://doi.org/10.3390/md16120499





